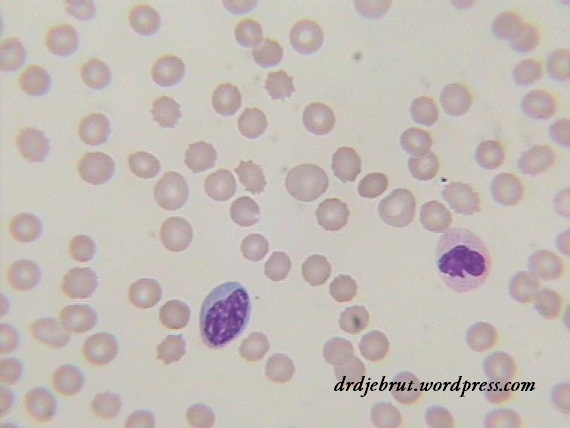

Trombositopenia dan Trombositosis
Saat terjadi wabah demam berdarah, mungkin kata-kata yang paling populer muncul adalah trombosit. “Bagaimana trombosit anak saya dokter?”, “Berapa kadar trombositnya dokter?” “Waduh, trombositnya turun terus ya dok?” Dan lain sebagainya. Pada kasus demam berdarah, memang dapat terjadi kadar trombosit yang turun atau istilahnya trombositopenia. Namun trombositopenia bukan milik demam berdarah saja, terdapat beberapa penyakit lain yang dapat menunjukkan kadar trombosit yang rendah. Begitu juga terdapat beberapa penyakit yang dapat menyebabkan peningkatan kadar trombosit di atas nilai normal atau disebut juga trombositosis.
Trombositopenia
Batas bawah kadar trombosit adalah 150.000/µl. Apabila tidak ada kelainan fungsi trombosit, jarang terjadi gejala perdarahan pada kadar trombosit antara 50.000-150.000/µl. Perdarahan spontan minor dan perdarahan setelah dilakukan tindakan pembedahan dapat terjadi pada kadar trombosit antara 20.000-50.000/µl, sedangkan perdarahan yang lebih serius bisa terjadi jika kadar trombosit turun sampai 0-20.000/µl. Penyebab dari trombositopenia bisa dibagi menjadi tiga yaitu menurunnya produksi, meningkatnya penghancuran, dan kelainan distribusi (hipersplenisme).
Perlu diperhatikan juga, kadang jumlah trombosit yang dihitung secara otomatis oleh mesin menunjukkan hasil yang rendah, padahal jumlah yang sebenarnya normal. Hal ini dapat terjadi karena adanya penggumpalan (clumping) trombosit setelah darah dicampurkan dengan antikoagulan EDTA yang menyebabkan trombosit tidak dapat disedot masuk ke dalam mesin. Jadi hasil ini perlu dikonfirmasi secara manual dengan hapusan darah tepi.
Penurunan produksi bisa disebabkan oleh infeksi virus (co: demam berdarah dengue), leukemia, kekurangan vitamin B12 dan asam folat, gagal hati, sepsis, dan beberapa kelainan bawaan seperti anemia Fanconi dan sindroma Alport. Sedangkan peningkatan penghancuran trombosit bisa terjadi pada ITP (Immune Thrombocytopenia), SLE (Lupus eritematosus sistemik), HUS (Hemolytic Uremic Syndrome), TTP (Thrombotic Thrombocytopenic Purpura), infeksi virus, perdarahan masif, obat-obatan, dan kelainan herediter yang lain.
Hapusan darah tepi menunjukkan kesan jumlah trombosit turun
Hapusan darah tepi menunjukkan kesan jumlah trombosit turun
Trombositosis
Peningkatan kadar trombosit biasanya merupakan akibat dari penyakit akut atau kronis yang lain (trombositosis reaktif). Penyebab yang sering adalah keganasan dan peradangan kronis, seperti arthritis rheumatoid. Penyebab yang lain adalah defisiensi besi dan splenektomi. Kadar trombosit biasanya dalam rentang 500.000-1.000.000/µl, tapi bisa juga lebih tinggi. Bahkan dari kasus bulan Agustus lalu, saya menemukan seorang pasien dengan kadar trombosit lebih dari 2.000.000/µl. Selain itu, kadar trombosit bisa meningkat akibat adanya peningkatan produksinya secara otonom pada penyakit mieloproliferatif, contohnya pada trombositosis esensial dan polisitemia vera.
Kesan jumlah trombosit yang meningkat disertai giant trombosit
Dapat kita lihat bahwa terdapat bermacam-macam penyebab terjadinya trombositopenia dan trombositosis pada seseorang. Sehingga dalam mencari penyakit yang mendasarinya perlu dilakukan anamnesis dan pemeriksaan fisik dahulu dan pemeriksaan penunjang lain yang mungkin diperlukan.
Semoga bermanfaat.






![[Download] Pedoman Nasional Pelayanan Kedokteran Tata Laksana Thalassemia (KMK)](/content/images/uploads/2022/10/KMK.jpg)
![[Download] Pemeriksaan Laboratorium pada Thalassemia](/content/images/uploads/2022/09/cover-web-scaled.jpg)